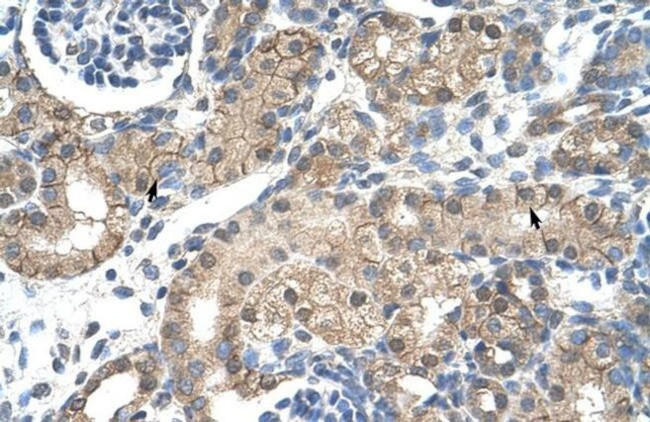
CHRNB2 Antibody in Immunohistochemistry (IHC)

Search
Invitrogen
CHRNB2 Polyclonal Antibody
{{$productOrderCtrl.translations['antibody.pdp.commerceCard.promotion.promotions']}}
{{$productOrderCtrl.translations['antibody.pdp.commerceCard.promotion.viewpromo']}}
{{$productOrderCtrl.translations['antibody.pdp.commerceCard.promotion.promocode']}}: {{promo.promoCode}} {{promo.promoTitle}} {{promo.promoDescription}}. {{$productOrderCtrl.translations['antibody.pdp.commerceCard.promotion.learnmore']}}
产品信息
PA5-40996
种属反应
宿主/亚型
分类
类型
抗原
偶联物
形式
浓度
规格
纯化类型
保存液
内含物
保存条件
运输条件
RRID
产品详细信息
Peptide sequence: CKIEVKHFPF DQQNCTMKFR SWTYDRTEID LVLKSEVASL DDFTPSGEWD
Sequence homology: Cow: 93%; Dog: 93%; Guinea Pig: 93%; Human: 100%; Mouse: 93%; Pig: 100%; Rat: 93%
靶标信息
Neuronal acetylcholine receptors are homo- or heteropentameric complexes composed of homologous alpha and beta subunits. They belong to a superfamily of ligand-gated ion channels which allow the flow of sodium and potassium across the plasma membrane in response to ligands such as acetylcholine and nicotine. This gene encodes one of several beta subunits. Mutations in this gene are associated with autosomal dominant nocturnal frontal lobe epilepsy.
仅用于科研。不用于诊断过程。未经明确授权不得转售。
篇参考文献 (0)
生物信息学
蛋白别名: acetylcholine receptor; acetylcholine receptor, nicotinic, beta 2 (neuronal); beta2 human neuronal nicotinic acetylcholine receptor; cholinergic receptor; cholinergic receptor, nicotinic beta 2; cholinergic receptor, nicotinic, beta 2 (neuronal); cholinergic receptor, nicotinic, beta polypeptide 2 (neuronal); Neuronal acetylcholine receptor subunit beta-2; neuronal nicotinic acetylcholine receptor beta 2; unnamed protein product
基因别名: CHRNB2; EFNL3; nAChRB2
UniProt ID: (Human) P17787
Entrez Gene ID: (Human) 1141